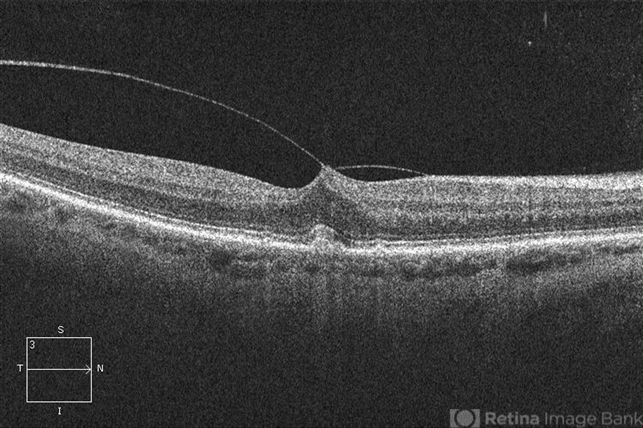

-
 By Alex P. Hunyor, MD
By Alex P. Hunyor, MD
Retina Associates - Uploaded on Dec 23, 2012.
- Last modified by Alex P. Hunyor, MD on Sep 28, 2013.
- Reviewed by Chayal Patel
- Rating
- Appears in
- Evolution and release of VMT
- Condition/keywords
- vitreomacular traction (VMT)
- Imaging device
- Optical coherence tomography system
- Description
- OCT at 8 months showing further development of focal VMT.

Initializing download.
Initializing download.










